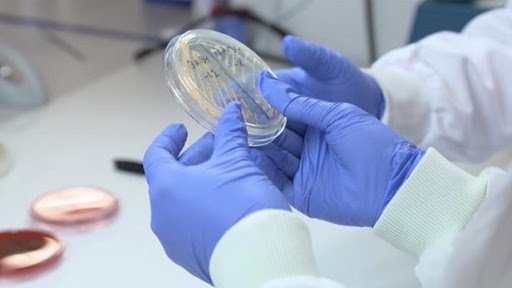

حذر خبراء من استخدام القفازات البلاستيكية للوقاية من فيروس كورونا، مشيرين إلى أنها تعطي شعورا زائفا بالأمان.
ونقلت وكالة دوغان، وفق ترجمة تركيا الان، عن الخبراء قولهم أن الفيروس يعيش على البلاستيك فترة أطول من غيرها.
بدوره يقول أخصائي الصحة والسلامة،يشيم ألتن تبة: “هذه القفازات تخلق شعوراً زائفاً بالأمان لدى الناس ، فعندما نخرج بالقفازات من المنزل ، نتمكن من لمس كل شيء دون خوف. وقد نقوم بلمس وجهنا وأعيننا دون وعي، وكلنا يعلم أن خطر الإصابة تكمن في الوجه”.
واضاف : “لا تنسوا ، فإساءة الاستخدام يهدد الصحة العامة، فاستخدام نفس القفازات من السوق إلى البنك ومنه إلى وسائل النقل العام يشكل خطراً كبيراً”.
وأشار إلى أن هناك قواعد معينة لاستخدام القفازات وأنه من الأفضل تطهير اليدين بالصابون والكولونيا والماء بدلاً من استخدام القفازات في مكافحة الفيروس.
ونوه أنه لا يجوز غسل القفازات واستخدامها مرارا وتكرارا. لا يمكن غسلها أو تعقيمها، كما لا يمكن التجول بها من مكان لآخر، يجب علينا اتباع المعلومات الصحيحة والتصرف بناء على المعرفة العلمية.
وأكد أن غسل اليدين بالماء والصابون لمدة 20 ثانية هو أفضل، لأنه عند ارتداء القفازات، يجب أن تغسل يديك قبل وبعد كل قفاز. لا يمكن تغيير القفازات عندما تغادر محل البقالة ، أو عندما تغادر البنك ، أو عند مغادرتك السوق، منبها الى غسل اليدين بالماء والصابون في المنزل ، والاحتفاظ بزجاجة كولونيا لاستخدامها كلما لزم الأمر، فالفيروس مغطى بطبقة من الزيت ، ولا يمكن القضاء عليه إلا من خلال الماء و الصابون أو الكحول”.
ويستخدم القفازات البلاستيكية على نطاق واسع من قبل المواطنين وخاصة موظفي السوق في نطاق التدابير المتخذة لمكافحة الفيروس.